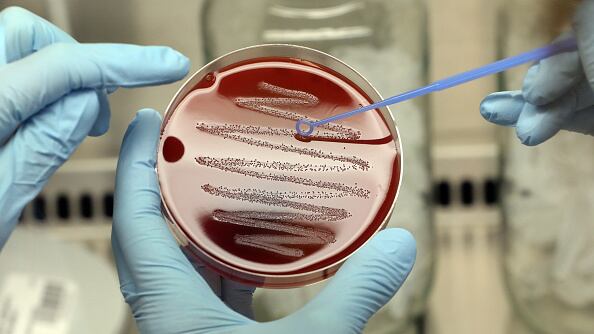

ATLANTA — The Centers for Disease Control and Prevention says a person from Georgia has died from a rare disease usually found in South Asia: Melioidosis.
The new death brings the total number of confirmed cases to four in different states. The cases have included adults and children. Two of the four patients had no known risk factors for melioidosis; two died.
None of the cases from Georgia, Kansas, Minnesota or Texas traveled internationally, puzzling experts.
[DOWNLOAD: Free WSB-TV News app for alerts as news breaks]
The CDC said it believes the most likely cause is an imported product (such as a food or drink, personal care or cleaning products or medicine) or an ingredient in one of those types of products.
The bacteria normally lives in moist soil and water. However, in rare cases, it has also been found to contaminate wet or moist products in the areas where the bacteria are common.
The CDC said the diagnosis is challenging because unlike the germs that cause most foodborne outbreaks, the bacteria responsible for melioidosis can take two to three weeks to make someone sick. This expands the window of time that investigators need to explore and means people may be less likely to remember everything they were exposed to before becoming ill. Each patient could have been exposed to potentially hundreds of products before they became ill.
The CDC is asking clinicians to watch for any acute bacterial infection that doesn’t respond to normal antibiotics and consider melioidosis – regardless of whether the patient traveled outside the U.S. The CDC also urges clinicians not to rule out melioidosis as a possible diagnosis in children and those who were previously healthy and without known risk factors for melioidosis.
TRENDING STORIES:
- No one injured as crews put out massive fire at popular Atlanta restaurant
- ICUs and ERs in crisis: Doctor warns that Georgia health care system is maxed out
- Employees at Nebraska Family Dollar all quit
Although healthy people may get melioidosis, underlying medical conditions may increase the risk of disease. The major risk factors are diabetes, liver or kidney disease, chronic lung disease, cancer or another condition that weakens the immune system.
Most children who get melioidosis do not have risk factors.
People experiencing cough, chest pain, high fever, headache or unexplained weight loss should see their doctor.
Signs and Symptoms
There are several types of melioidosis infection, each with their own set of symptoms.
However, it is important to note that melioidosis has a wide range of signs and symptoms that can be mistaken for other diseases such as tuberculosis or more common forms of pneumonia.
Localized Infection:
- Localized pain or swelling
- Fever
- Ulceration
- Abscess
Pulmonary Infection:
- Cough
- Chest pain
- High fever
- Headache
- Anorexia
Bloodstream Infection:
- Fever
- Headache
- Respiratory distress
- Abdominal discomfort
- Joint pain
- Disorientation
Disseminated Infection:
- Fever
- Weight loss
- Stomach or chest pain
- Muscle or joint pain
- Headache
- Central nervous system/brain infection
- Seizures
The time between an exposure to the bacteria that causes the disease and the emergence of symptoms is not clearly defined but may range from one day to many years; generally, symptoms appear two to four weeks after exposure.
Although healthy people may get melioidosis, underlying medical conditions may increase the risk of diseases. The major risk factors are:
- Diabetes
- Liver disease
- Renal disease
- Thalassemia
- Cancer or another immune-suppressing condition not related to HIV
- Chronic Lung disease (such as cystic fibrosis, chronic obstructive pulmonary disease (COPD), and bronchiectasis)
[SIGN UP: WSB-TV Daily Headlines Newsletter]
©2021 Cox Media Group